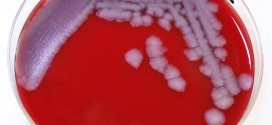
Scientists possibly exposed to anthrax : CDC

A study from the University of Waterloo has found that more than half of Canadian teens using tobacco are going for flavoured products like bubble-gum or cherry. The study also found that among students who reported smoking cigarettes in the 30 days prior to the survey, 32 per cent chose to puff on menthol-flavoured brands.
Read More »World
Crisis at Surrey Memorial Hospital: BC nurses
Surrey Memorial nurses say despite the hospital upgrades, the emergency ward is still in crisis. BC Nurses Union Steward Gail Conlin says the new emergency department is facing issues of overcrowding, long wait times, and hallway medicine. “I do not believe as a nurse myself opening the critical care tower with the critical care units wouldn’t necessarily offload or decant …
Read More »City of Montreal to address high levels of noise pollution, Report
The city says it will work with Montreal’s public health agency to start a committee, before the end of the year, which will discuss solutions to the noise pollution problem across the island. The committee will work with partners such as Transport Quebec, CN and the Montreal airport to figure out what can be done to bring down noise levels.
Read More »Texas Man infected teen with HIV
A sentence of up to 95 years could be handed down Wednesday for a man with AIDS who pleaded guilty to sexual assault of a 15-year-old girl. The girl and her mother gave emotional testimony Tuesday at the sentencing hearing for Matthew Louis Reese. Names of the victim and her family are being withheld because she is a minor and …
Read More »TV couple charged in wedding theft (Video)
A maid of honor and her husband, who once appeared on the reality series, “My Big Fat American Gypsy Wedding,” were arrested following a wedding Sunday for allegedly stealing from the bride.
Read More »Marilyn Monroe Statue Dumped
The giant statue of Marilyn Monroe striking her iconic pose in Guigang of Guangxi Zhuang Autonomous Region has been torn down and left at a dump site.
Read More »Scientists possibly exposed to anthrax : CDC
About 75 scientists may have been exposed to live anthrax bacteria in U.S. government laboratories in Atlanta and are being treated to prevent the infection, the federal Centers for Disease Control and Prevention said Thursday.
Read More »Tim McGraw Shows Off 8-Pack Abs (Photo)
Tim McGraw quit drinking after his wife told him he’s ‘gone too far.’ But not only has sobriety impacted his intimate relationships, it’s affected his physical appearance – for the best. Stripping down to a pair of light grey tracksuit shorts, the 47-year-old country crooner showed off his impressive form in the newest issue of Men’s Health Magazine.
Read More »Andressa Urach : Brazilian model continuing Cristiano Ronaldo obsession?
Andressa Urach, aka Miss Bum Bum, was escorted away from a Portugal training session yesterday. The big-bottomed beauty has been stalking Cristiano Ronaldo with a microphone throughout the FIFA World Cup in Brazil.
Read More »Honey Boo Boo a ‘monster’?
A firsthand account of Honey Boo Boo‘s recent visit with Jimmy Fallon sounds almost nothing like what Tonight Show viewers were presented. Christy O’Shoney, a writer for Salon who was in the audience during the Here Comes Honey Boo Boo stars’ taping Wednesday, explains “from where I was sitting, Honey Boo Boo — let’s not mince words — was a …
Read More »Idina Menzel owns this wardrobe malfunction (Video)
Idina Menzel, or Adele Dazeem (as John Travolta once referred to her), really knows how think on her feet, judging from the way she handled a wardrobe malfunction during a performance at Radio City Music Hall in New York on Monday.
Read More » Canada Journal – News of the World Articles and videos to bring you the biggest Canadian news stories from across the country every day
Canada Journal – News of the World Articles and videos to bring you the biggest Canadian news stories from across the country every day